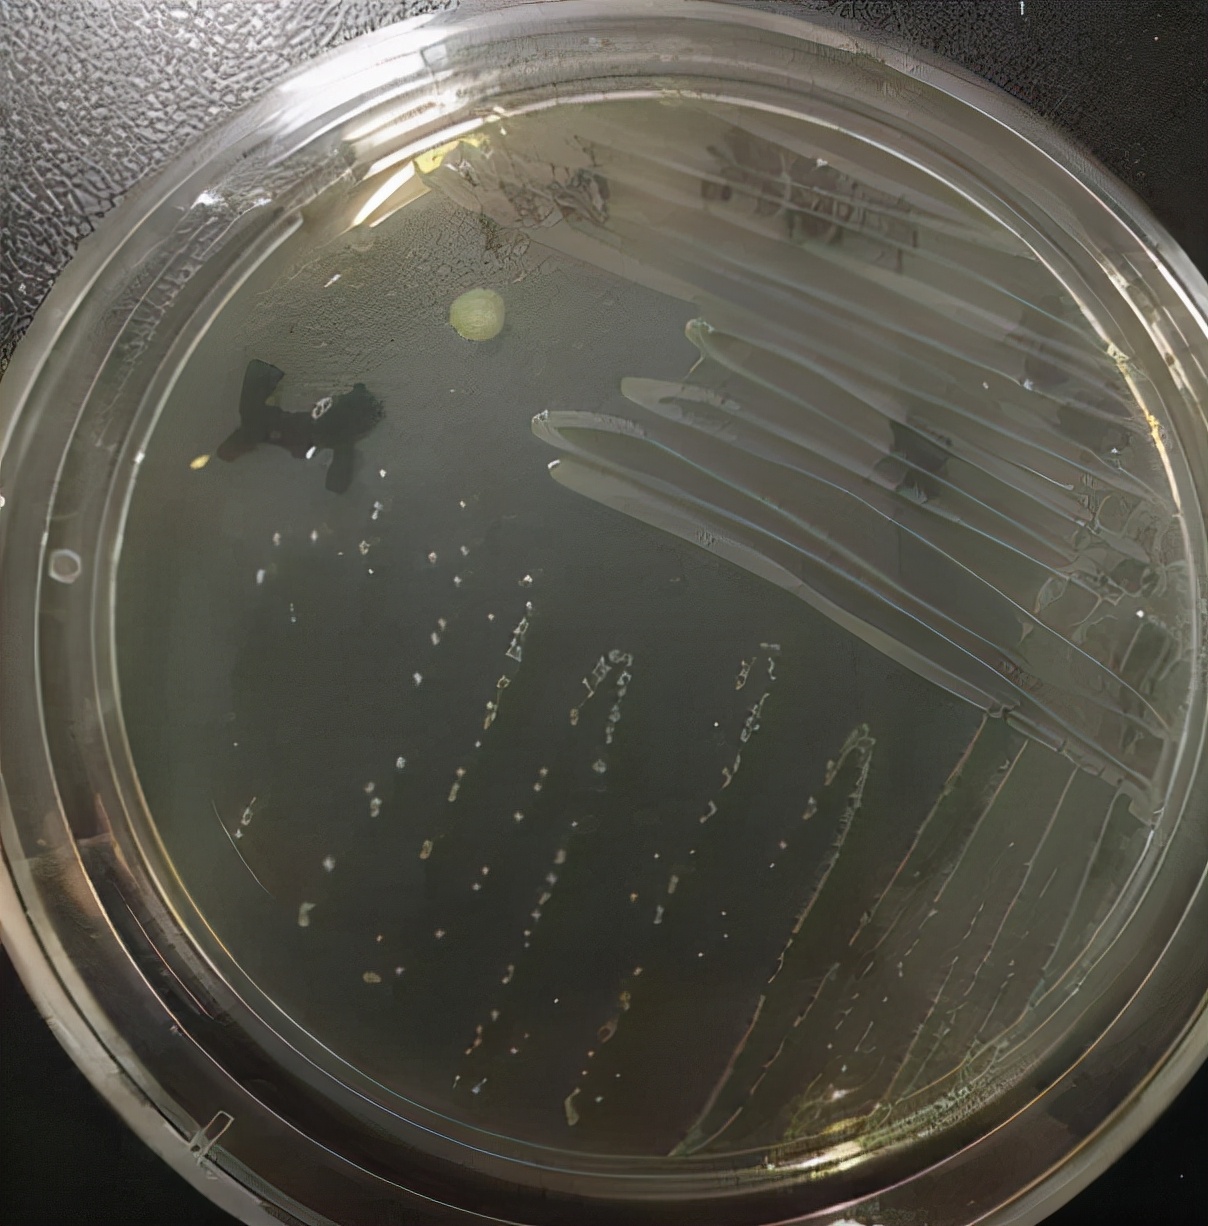
黄骨鱼出血病下什么药,黄骨鱼内脏出血是怎么回事

东佛山高明区一养殖杂交黄颡鱼池塘,水面面积8亩,水深1.5米,4台1.5kW叶轮增氧机、1台1.5kW水车增氧机(图1)。存塘鱼30万尾左右,“鱼头”4两/尾,日常投喂两餐,早、晚各4包料,共320斤。

阿图1 发病池塘
2021年4月15日,吃料减慢,当天死鱼10多尾。
4月16日,当天死鱼约20斤。发病鱼体表光滑,主要表现为游水、红肛门、“大肚子”、腹水严重、肠道充血等症状。上午9点“海控在手”检测溶氧4.86mg/L,饱和度52%,水温24.3℃;快速水质测试盒检测pH值6.5,亚硝酸盐2.0mg/L,氨氮0.4mg/L。当天捞6尾游水鱼,接种肝、脾、肾等部位于TSA培养基进行细菌分离培养,16S rDNA测序鉴定优势菌落为爱德华氏菌属( Edwardsiella )。
4月17日,上午全塘外泼6包“速解安”+5斤“底加氧”,尝试投喂,鱼基本不开口,建议停料5-7日,当日开始停料。死鱼约100斤。
4月18-20日,每天死鱼200斤左右,期间外用杀菌药物。
4月21日,死鱼约240斤,解剖发现游水鱼鳃丝暗红充血,肝脏黄褐色,肾脏淤血,脾脏发黑。死鱼大部分为“大肚子”、腹水,少部分胸鳍、尾鳍点状充血。根据症状初步怀疑为爱德华氏菌与链球菌混合感染,亚硝酸盐高造成大量死鱼。当天鱼中看鱼,并决定于23日出鱼。
4月22日,上午使用6包“速解安”+8包“激活”+15斤“底加氧”。
4月23日,下午开始排水,晚上11点开始起网。由于当天大车进不了村道,塘主决定不卖鱼,过鱼到隔壁塘。
4月24日半夜至25日凌晨,过塘约3万斤鱼,当晚情况良好,约100尾死鱼。
4月25日,晴,死鱼100斤。外用碘和药物B(硫醚沙星)消毒。
4月26日,小雨,死鱼1000斤。发病鱼头上、尾下斜游,打转,“飚水”后定身“吊颈”(图2),靠边,鳍条、体表可见点泡状充血(图3~5),鳃丝色淡、点状充血(图6),肝脏发黄,脾脏色淡,空肠空胃。下午6点检测水质,氨氮1.2mg/L,亚硝酸盐0.6mg/L,pH值7.8;溶氧3.85mg/L,饱和度46.4%,水温25.4℃。水质黄绿较为清爽。捞4尾游水鱼,接种肝、脾、肾等部位于TSA培养基进行细菌分离培养,经42h室温培养,形成灰白色、圆形、稍凸起的小菌落(图7),革兰氏阳性,球状,短链状排列,无芽孢(图8),经16S rDNA测序鉴定为链球菌属( Streptococcus )的细菌。

图2 发病鱼打转、“飙水”后“吊颈”

图3 发病鱼尾鳍呈血泡状充血

图4 发病鱼背鳍呈血泡状充血

图5 发病鱼体表、胸鳍呈血泡状充血

图6 发病鱼鳃丝色淡、点状充血
图7 4月26日细菌分离结果

图8 纯化优势菌革兰氏染色结果
4月27日,小雨,死鱼约2000斤,大量游水鱼。
4月28日,小雨,死鱼约5000斤。
4月29日,晴,死鱼约6000斤。
4月30日,晴,死鱼约2000斤。
5月1日,晴,死鱼约1000斤。
5月2日,晴转暴雨,死鱼100斤,症状同26日。料台处聚集大量鱼,活力正常。下午3点40分检测水质,氨氮1.2mg/L,亚硝酸盐0.8mg/L,pH值7.8;溶氧3.77mg/L,水温29.5℃,饱和度51.7%。水质黄绿、浑浊。
5月3日,小雨。投喂20斤料,死鱼70斤左右。
5月4日,晴。投喂40斤料,死鱼较前一日有所减少。
5月8日,投喂80斤料/天,基本无死鱼。
期间累计死亡量约17200斤,死亡率约57%。
分 析 :
1、该病例过塘前鱼先是感染爱德华氏菌引起死鱼,随着病情发展,部分发病鱼出现体表、鳍条点泡状充血的链球菌病症状。期间持续死亡时间长,呈慢性发病。
2、4月23日鱼带病过塘,水变应激后体质弱,加之过塘后使用消毒药物及雨天溶氧低,这些诱因加速病情发展,转为急性发病,鱼大量死亡。随着水温升高,过塘后鱼主要以感染链球菌为主,出现打转、“飙水”等急性神经性症状。